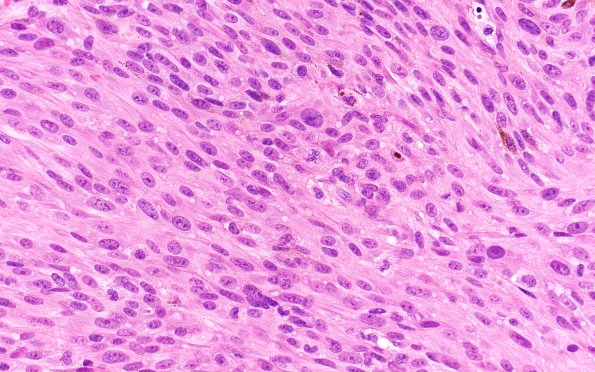
10A2 Melanoma (Case 10) H&E 40X

Table of Contents
Washington University Experience | NEOPLASMS (METASTASES) | Melanoma | 10A2 Melanoma (Case 10) H&E 40X
H&E stained sections show a high-grade malignant neoplasm composed of prominently spindled cells with moderate pleomorphism and indistinct cell borders. The tumor cells have a small to moderate amount of eosinophilic cytoplasm, and many show 'cherry red' nucleoli. The background tissue shows frequent deposits of melanin pigment including in macrophages. (H&E)